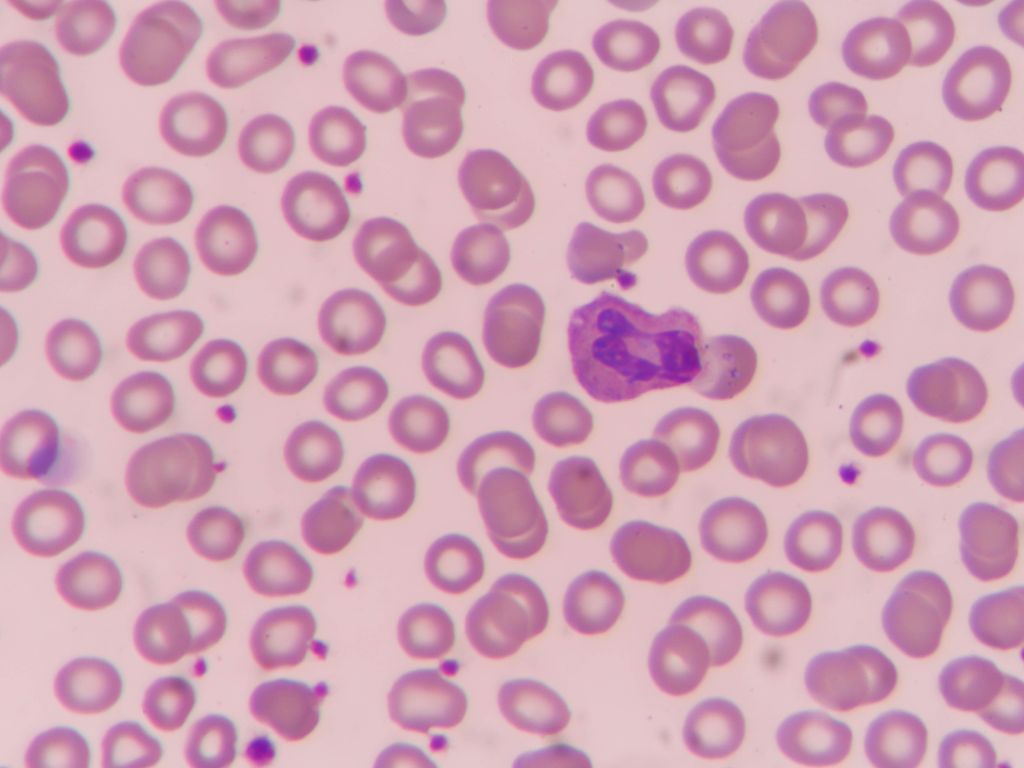
malaria

La compañía Grifols ha anunciado la obtención de la aprobación por parte de la Administración de Alimentos y Medicamentos de Estados Unidos (FDA) para su ensayo de cribado de malaria Procleix Plasmodium, diseñado para su uso en el sistema automatizado Procleix Panther. Esta prueba, que ya obtuvo el marcado CE en 2022, se convierte en el primer análisis de amplificación de ácidos nucleicos (NAT) validado específicamente para el cribado de donantes de sangre en el mercado estadounidense.
El ensayo Procleix Plasmodium utiliza tecnología de captura magnética y amplificación mediada por transcripción para detectar ARN ribosómico de las cinco especies de parásitos del género Plasmodium que afectan a humanos (P. falciparum, P. knowlesi, P. malariae, P. ovale y P. vivax). A diferencia de los métodos tradicionales basados en cuestionarios de viaje que excluyen temporalmente a los donantes, este sistema permite una detección directa y altamente sensible del patógeno, incluso en donantes asintomáticos, reduciendo el riesgo de transmisión transfusional.
La implementación de esta tecnología en el sistema Procleix Panther permite a los bancos de sangre automatizar íntegramente el proceso NAT en una plataforma integrada. Según ha informado la compañía, el uso de muestras de sangre completa y la capacidad de detectar miles de copias de ARN por parásito mejoran la seguridad de los componentes sanguíneos frente a una enfermedad que causa anualmente más de 280 millones de infecciones a nivel global.